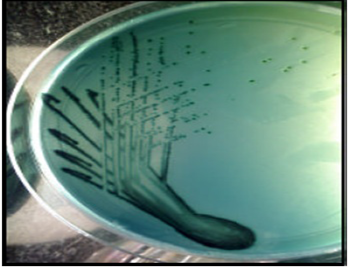

Journal of Animal Health and Production
Research Article
J. Anim. Health Prod. 5(2): 74-78
Figure 1
The colonies of Salmonella on selective media
Figure 2
Triple Sugar Iron (TSI) test
Figure 3
Urease test
Figure 4
The antimicrobial susceptibility pattern of Salmonella isolates